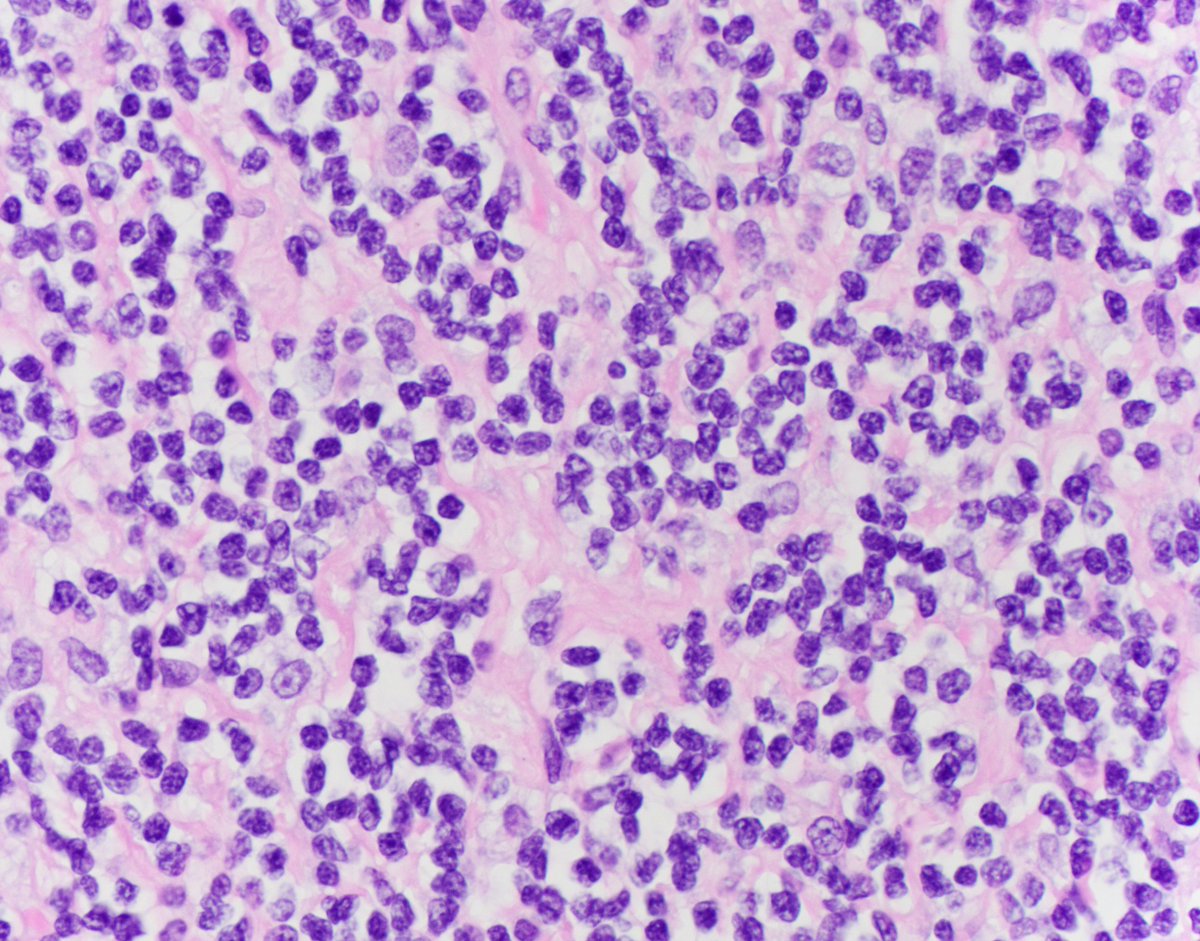
HubertLauMD's tweet image. Wow, I haven&apos;t posted anything in a long time.

Here are some CLASSIC cleaved cells of follicular lymphoma.

I personally find it easier to appreciate the cleaved morphology on air-dried cytology smears than on H&amp;amp;E. What do you think? #HemePath #CytoPath #FNAPath

#fnapath risultati di ricerca










You can run, but you can't hide: metastatic pancreatic adenocarcinoma hiding amongst benign hepatocytes #CytoPath #FNApath

New review article provides updates in the histology, cytology, molecular biology, and treatment of salivary duct carcinoma bit.ly/2XcmP77 #FNApath #cytopath






Living up to their name: Multinucleated giant cells in granulomatous lymphadenitis #FNApath #CytoPath


Expression of MDM2 and p16 in Angiomyolipoma ow.ly/UF6o30ineD4 via @Human_Pathology #FNApath #RenalPath

How would you describe this pattern of necrosis on an #FNApath #CytoPath smear? I always thought it looked like a bunch of worms🪱. Histologic correlate in third picture.



Submandibular mass FNA. What is the pattern, and what is your differential diagnosis? #FNAfriday #FNApath #Cytopath #ENTpath








#FNApath #Cytopath 79 y/o woman. Suspicious adrenal mass. History of breast and Lung Ca. EUS biopsy shows blood and some clusters of very bland cells. Opinion ?



Papillary thyroid carcinoma!!! 🎈Most common thyroid cancer 🎈F>M 🎈3rd-5th decade 🎈Good prognosis 🎈Activation of MAPK pathway by point mutations of BRAF or of RAS expression of receptor tyrosine kinase #FNApath #ENDOpath #pathtwitter




A 56 y/o female presents with a progressively hard left buccal mass with swelling and mild pain on compression. Just receive this case after I saw the post from @JaylouVelez Dx: foreign body granulomatous reaction to Radiesse (calcium hydroxylapatite) #FNApath #cytopath




FNAC is a highly accurate and specific test for lymph node (LN) pathology, especially in the pediatric population. The incorporation of the Sydney system helps to achieve uniformity and reproducibility in LN cytology diagnosis. acsjournals.onlinelibrary.wiley.com/doi/full/10.10… #CytoPath #FNAPath





New! FNAC is a highly accurate and specific test for lymph node (LN) pathology, especially in the pediatric population. The incorporation of the Sydney system helps to achieve uniformity and reproducibility in LN cytology diagnosis. acsjournals.onlinelibrary.wiley.com/doi/full/10.10… #CytoPath #FNAPath

Happening at 8:00am! Join our EIC @bfaquin, Associate Editor @DianaEstherossi, and EB member @aakasharmand in their Short Course spotlighting recent challenges and lessons learned in fine-needle aspiration of head and neck cystic lesions. #ASCyto24 #FNAPath

Commentary: Challenging the concept of “risk of malignancy” in cytology acsjournals.onlinelibrary.wiley.com/doi/full/10.10… #CytoPath #FNAPath @NikasIlias

Commentary: Challenging the concept of “risk of malignancy” in cytology acsjournals.onlinelibrary.wiley.com/doi/full/10.10… #CytoPath #FNAPath @NikasIlias

This new meta-analysis showed that the @MilanSystem works well in FNA cytopathology practice and improves diagnostic accuracy in all diagnostic categories. Available #OpenAccess: acsjournals.onlinelibrary.wiley.com/doi/full/10.10… @IvanaKholova @DavidKalfert @ZMaleki_cyto #cytopath #fnapath

New and #OpenAccess | Medullary #thyroid carcinoma can be detected earlier via Calcitonin measurement in serum and aspiration needle washout fluids. 🔗acsjournals.onlinelibrary.wiley.com/doi/full/10.10… #FNApath #CytoPath #ASCyto23

#Cytopath #FNApath #Pathology 70 y/o man with Urine cytology. History not provided. It is hemorrhagic with some atypical cells. I am very concerned. Your opinion......




Check out this great overview from our sister journal @CAonline of the new and existing research on salivary gland cancers, including a shout-out of the #MilanSystem! @bfaquin @DianaEstherossi #CytoPath #FNApath #HNCSM #ENTpath
This new review article highlights standards of care as well as exciting new research for salivary gland cancers that will strive for better patient outcomes. acsjournals.onlinelibrary.wiley.com/doi/full/10.33… @ConorSteuerMD @HeadNeckMD @JamesBatesMD @AlanHoMDPhD @DrNabilSaba @winshipatemory

Read this new commentary by @twmarkc on practical issues of small-volume biopsy of follicular lymphoma: acsjournals.onlinelibrary.wiley.com/doi/full/10.10… @mdlozanoe @MozeticV @SamKhader @barkanga @EfcsYoung @aakasharmand @sza_jhcyto #cytopath #fnapath #hematology #lymphoma

Read this new commentary by @twmarkc on practical issues of small-volume biopsy of follicular lymphoma: acsjournals.onlinelibrary.wiley.com/doi/full/10.10… @mdlozanoe @MozeticV @SamKhader @barkanga @EfcsYoung @aakasharmand @sza_jhcyto #cytopath #fnapath #hematology #lymphoma

#FNApath #Cytopath 79 y/o woman. Suspicious adrenal mass. History of breast and Lung Ca. EUS biopsy shows blood and some clusters of very bland cells. Opinion ?



Beautiful tyrosine crystals in a pleomorphic adenoma (ThinPrep) #CytoPath #FNApath #ENTpath Photo credit: @PathologyBadBoy


Wow, I haven't posted anything in a long time. Here are some CLASSIC cleaved cells of follicular lymphoma. I personally find it easier to appreciate the cleaved morphology on air-dried cytology smears than on H&E. What do you think? #HemePath #CytoPath #FNAPath

Expression of MDM2 and p16 in Angiomyolipoma ow.ly/UF6o30ineD4 via @Human_Pathology #FNApath #RenalPath






New review article provides updates in the histology, cytology, molecular biology, and treatment of salivary duct carcinoma bit.ly/2XcmP77 #FNApath #cytopath









Dr. Rohit, @GIlymphomapath @ClevelandClinic review EUS-FNA of GI spindle cell neoplasms including a novel case of gastric plexiform fibromyxoma: ow.ly/L7Jr30mmp35 #GIPath #FNApath

Nódulo en clítoris en una mujer con antecedente de melanoma vulvar. ▶️ Binucleaciones -->> 👽👽👽👽 ▶️ SOX10, Melan A y S100 +. Recidiva de melanoma. #FNApath #cytopathology


You can run, but you can't hide: metastatic pancreatic adenocarcinoma hiding amongst benign hepatocytes #CytoPath #FNApath








Living up to their name: Multinucleated giant cells in granulomatous lymphadenitis #FNApath #CytoPath


How would you describe this pattern of necrosis on an #FNApath #CytoPath smear? I always thought it looked like a bunch of worms🪱. Histologic correlate in third picture.



New from Paul E. Wakely MD (@OSUWexMed) | Salivary duct carcinoma: A report of 70 FNA cases and review of the literature ow.ly/4n1i50IcW1B #CytoPath #FNAPath #MilanSystem

#FNApath #Cytopath 79 y/o woman. Suspicious adrenal mass. History of breast and Lung Ca. EUS biopsy shows blood and some clusters of very bland cells. Opinion ?



Papillary thyroid carcinoma!!! 🎈Most common thyroid cancer 🎈F>M 🎈3rd-5th decade 🎈Good prognosis 🎈Activation of MAPK pathway by point mutations of BRAF or of RAS expression of receptor tyrosine kinase #FNApath #ENDOpath #pathtwitter




Something went wrong.
Something went wrong.
United States Trends
- 1. #AEWFullGear 30.5K posts
- 2. Benavidez 11.2K posts
- 3. Haney 23.4K posts
- 4. Georgia Tech 5,208 posts
- 5. Terry Smith 1,504 posts
- 6. Narduzzi 1,140 posts
- 7. Nebraska 22.8K posts
- 8. Moxley 2,524 posts
- 9. #TheRingIV 9,887 posts
- 10. Claudio 20.1K posts
- 11. Rhule 1,606 posts
- 12. Haynes King 1,159 posts
- 13. #RiyadhSeason 15.9K posts
- 14. #Boxing 9,605 posts
- 15. Rose Lavelle 1,101 posts
- 16. Kyle O'Reilly 1,143 posts
- 17. #Svengoolie 1,705 posts
- 18. Brian Norman 6,970 posts
- 19. Bivol N/A
- 20. Darby 4,024 posts































